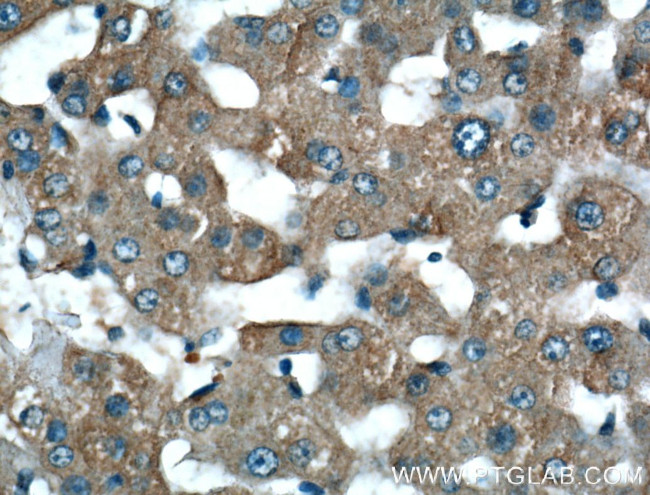
LSR Antibody in Immunohistochemistry (Paraffin) (IHC (P))

Search
Proteintech
LSR Polyclonal Antibody
{{$productOrderCtrl.translations['antibody.pdp.commerceCard.promotion.promotions']}}
{{$productOrderCtrl.translations['antibody.pdp.commerceCard.promotion.viewpromo']}}
{{$productOrderCtrl.translations['antibody.pdp.commerceCard.promotion.promocode']}}: {{promo.promoCode}} {{promo.promoTitle}} {{promo.promoDescription}}. {{$productOrderCtrl.translations['antibody.pdp.commerceCard.promotion.learnmore']}}
产品信息
18216-1-AP
种属反应
宿主/亚型
分类
类型
抗原
偶联物
形式
浓度
规格
纯化类型
保存液
内含物
保存条件
运输条件
产品详细信息
Immunogen sequence: SMRVLYYME KELANFDPSR PGPPSGRVER AMSEVTSLHE DDWRSRPSRG PALTPIRDEE WGGHSPRSPR GWDQEPAREQ AGGGWRARRP RARSVDALDD LTPPSTAESG SRSPTSNGGR RSRAYMPPRS RSRDDLYDQD DSRDFPRSRD PHYDDFRSRE RPPADPRSHH HRTRDPRDNG SRSGDLPYDG RLLEEAVRKK GSEERRRPHK EEEEEAYYPP APPPYSETDS QASRERRLKK NLALSRESLV V (339-589 aa encoded by BC004381)
靶标信息
Lipolysis-stimulated lipoprotein receptor (LSR), encoded by the LSR gene, is a crucial component in lipid metabolism, particularly involved in the endocytosis of triglyceride-rich lipoproteins. It is typically expressed in liver and adipose tissues, playing a pivotal role in maintaining lipid and glucose homeostasis. LSR binds to lipoproteins in the presence of free fatty acids, facilitating the uptake and clearance of lipids from the bloodstream, which is significant in preventing atherosclerosis and other lipid-related disorders. The protein functions as a multi-subunit complex, which includes two isoforms, LSRα and LSRβ, each contributing to lipoprotein metabolism. Research has highlighted its involvement in metabolic processes and its potential impacts on obesity and insulin resistance. LSR has also been studied in the context of hepatic lipid accumulation, where its downregulation is associated with increased lipid deposition in the liver, suggesting its importance in preventing non-alcoholic fatty liver disease (NAFLD). Due to its central role in lipid metabolism, LSR has emerged as a potential therapeutic target for metabolic diseases and cardiovascular conditions.
仅用于科研。不用于诊断过程。未经明确授权不得转售。
生物信息学
蛋白别名: Angulin-1; Angulin-3; immunoglobulin-like domain containing receptor 3; lipolysis stimulated receptor; Lipolysis-stimulated lipoprotein receptor; Lipolysis-stimulated receptor; lipolysis-stimulated remnant; Lipolysis-stimulated remnant receptor; LISCH protein; Liver-specific bHLH-Zip transcription factor; liver-specific bHLH-Zip transcription factor 7; Liver-specific gene on mouse chromosome 7 protein; unnamed protein product
基因别名: ILDR3; LISCH; LISCH7; LSR
UniProt ID: (Human) Q86X29, (Rat) Q9WU74, (Mouse) Q99KG5
Entrez Gene ID: (Human) 51599, (Rat) 64355, (Mouse) 54135